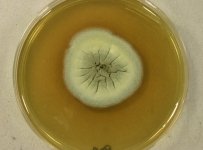
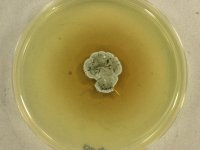

Search Details
| UAMH Number: | 11254 |
|---|---|
| Species Name: | Aspergillus insolitus |
| Type: | Polypaecilum insolitum |
| Synonyms: | Polypaecilum insolitum / Scopulariopsis divaricata / Scopulariopsis divaricata var. alba / Scopulariopsis insolita |
| Taxonomy: | FUNGI Ascomycota, Eurotiomycetes, Eurotiales, Aspergillaceae |
| Strain History: | C.J. La Touche (No. SC150) -> CBS 384.61 -> UAMH |
| Substrate: | ear, man | Location: | UNITED KINGDOM England, Yorkshire, Leeds, United Leeds Hospital (GEO: 53.802,-1.554) |
| Isolator: | C.J. La Touche (No. SC150) |
| Isolation Date: | 1961-11-01 |
| Date Received: | 2010-08-03 |
| Characters: | CULTURE CONDITIONS grows better @ 30C than @ 35C - fide UAMH 2010 // MOLECULAR SYSTEMATICS phylogeny of Penicillium and related taxa in the Trichocomaceae - Houbrakken J, Samson RA, Stud Mycol 70:1-51, 2011 // PIGMENT yellow on PDA - // SYSTEMATICS/ TAXONOMY Whole genome sequence available - (Click for publications citing UAMH 11254) |
| Compounds: | |
| Cross Reference: | ATCC 18164 // CBS 384.61 // IFO 8788 // IMI 075202 // LSHB BB414 // MUCL 3078 // QM 7961 |
| Collections: | Living Strains; Dried Herbarium Material |
| Pathogenic Potential: | Human: yes | Animal: yes | Plant: no |
| Biosafety Risk Group: | RG2 (check the PHAC ePATHogen Risk Group Database for updates) |
| Regulatory Requirements: | Canadian requesters must provide PHAC Pathogen and Toxin License Number (see: https://www.canada.ca/en/public-health/services/laboratory-biosafety-biosecurity/licensing-program.html) prior to shipment. International requesters must provide all legally required importation documentation prior to shipment. Plant pathogenicity status may be verified by using the USDA Agricultural Research Service (ARS) Fungal Database |
| MycoBank ID: | 809591 |
| Sequences: | >UAMH11254_JN121911_Cct8 ACCCAGAAGGCCAAGGTGGGCGTGTTTAGCTGCCCAATTGATGTTAGCCAGACCGAGACCAAGGGAACAGTGCTTTTGAAGAACGCGCAGGAGATGCTCGACTACACTAAGGGAGAGGAGGAACGTCTTGAGGCGGCTATCAAGGAACTCTACGATTCGGGGATTCGTGTGGTCGTTGCGGGTGCGACTGTCGGTGACCTAGCTCTCCACTACCTTAACCGCTTCAATATTCTTGTGATTAAGATCTTGTCGAAGTTCGAGCTCCGCCGACTCTGCCGTGTCGTCGGTGCTACGCCTCTTGCTCGTTTGGGGGCACCTATGCCGGACGAGATGGGTAGCGTGGATGTGGTCGAGACCACGGAAATTGGCGGAGACCGAGTCACCGTGTTCCGTCAAGAAGACCCCAACACTGTCACACGCACAGCTACCATCGTCCTGCGTGGAGCGACCCAGAACCACCTGGAGGACGTCGAGCGTGCTATTGACGACGGGGTTAACGCTATCAAAGCGATCACCAAGGACCCGCGTCTCGTTCCTGGCGCTGGAGCCACTGAGATCCAGCTCTTAGAACGAATCTCGGCGTTTGCGGACAAGACGCCTGGGCTACCCCAGCATGCGATTCGGAAGTTCGCCGAGGCGTTCGAAGTGATTCCTCGTACGCTTGCCGAGTCTGCCGGGTTAGATGCCACGGAGGTGCTTTCTCGCCTGTACACA >UAMH11254_UAMH_ITS CATTACCGAGCGTTTGGCAGCCCTGTTCCAGGGTTGCCTACCTCCCACCCGTGACTACCGTACCTTGTTGCTTCGGCGGGCCGCCGTCAGGCCCCCGGGGCGGGGGAGAAATCCCCCCCCTTCCGGGGCAGCGCCCGCCGGAGACACCTTGAAACTCTTTGTGTGAAGATTGCCTCTGAGTTTGACACAAAATAGCCAAAACTTTCAACAACGGATCTCTTGGTTCCGGCATCGATGAAGAACGCAGCGAACTGCGATAAGTAATGTGAATTGCAGAATTCAGTGAATCATCGAGTCTTTGAACGCACATTGCGCCCCCTGGTATTCCGGGGGGCATGCCTGTCCGAGCGTCATTGCTACCCTCCAGCACGGCTGGTGTGTTGGGCGCCGCGTCCCCTCCCCTTCCGGGGGGGACGGGCCCGAAAGGCAGCGGCGGCACCGTCCGGTCCTCGAGCGTATGGGGCTTTGTCACCCGCTCTGCAGGGCCGGCCGGGGCTCGCCTCGACAGTCAGTCTTCTTTTTTTTCTAAGGTTGACCTCGGATCAGGTAGGGATACCCGCTGAACTT >UAMH11254_JN121667_RNApol2 GTGTCTCCACAGCGAAATGGTCCCCTCATGGGTATTGTGCAAGATACCCTTTGTGGTATCTACAAGATTTGTCGGCGTGACGTTTTCCTATCCAGAGAACAAGTGATGAATATCATGCTCTGGGTTCCAGACTGGGATGGTGTTCTGCCACCGCCAGCTATTGTGAAGCCTCGGCCGCGATGGACCGGGAAGCAGATGATTAGCATGGCGCTTCCATCGGGTCTGAACCTCCTTCGTGTCGACAAGGACAATTCGGCTCTCTCCGAGAAGTTTTCCCCTCTTAACGATGGCGGATTGCTCATACACAGTGGACAGGTGATGTATGGAATGTTCTCTAAGAAGACTGTTGGCGCTAGTGGTGGTGGCGTTGTCCATACCATTTACAATGAGTATGGACCAGATGCTGCTGTCGCTTTCTTCAACGGCGCTCAGACCATTGTCAACTACTGGTTGTTACATCATGGGTTCAGTATTGGCATTGGCGACACGATTCCGGATCCGTCCACGATTCAGAGAATCGAGAATTGTGTTCGCAACCGCAAACAGGAAGTCGAATCTATAACCGCGAGTGCGACTGATAACACTCTCGAGGCGTTACCCGGTATGAATGTGCGAGAAACTTTCGAAAGCAAGGTCTCGCGTGCCCTCAACAATGCCCGTGATGAAGCTGGTGGCGAAACCGAGAAGAGCTTGAAGGATCTTAACAACGCCATCCAGATGGCACGTTCTGGATCCAAGGGATCGACTATTAACATTTCCCAGATG >UAMH11254_JN121510_RNApol2 AGGTGTGTTGAGAGTGGCAAGGATATTTATATGAATATTGGTGTAAAGGCCAGCACGTTGAGCTCGGGCTTGAAGTATGCTCTTGCCACAGGAAACTGGGGTGAGCAGAAGAAGGCAGCAAGCTCGAAGGCTGGTGTGTCGCAAGTACTCAGTCGATACACCTACGCGTCTACATTGTCACATCTTCGCCGGACCAACACGCCCATCGGCCGTGACGGAAAGATCGCGAAGCCACGCCAGCTTCACAACACGCACTGGGGCTTGGTCTGTCCGTCCGAAACTCCGGAAGGTCAAGCCTGCGGTCTCGTGAAGAATCTGGCGCTCATGTGCTACATCACCGTTGGTACGCCCAGCGAGCCGATCATCGACTTCATGATCCAGCGCAACATGGAGGTACTCGAGGAGTTCGAGCCCCAGGTGACGCCGAATGCAACAAAGGTGTTTGTGAACGGTGTCTGGGTAGGAATCCACCGTGATCCGTCTCATCTTGTTAACACCATGCTGTCGCTGCGCCGGCGGAACATGATTTCGCACGAGGTCAGTTTGATTCGGGACATCCGAGAGCGGGAGTTCAAGATCTTCACGGATGCCGGCCGTGTATCACGACCGCTGTTCGTTATCGACAACGACCCGAAGAGCGAGAACTCCGGCTCGTTAGTCCTTAATAAAGAGCATATCCGTAAATTGGAGGAAGATAAGGAATTGCCGCCCGACCTGGACCCCGAAGAGCGGAGAGAGCGCTATTTCGGATGGGATGGTCTTGTCAAATCTGGAGTTGTCGAATATGTCGATGCTGAGGAAGAGGAGACGATCATGATCGTGATGACCCCTGAAGACCTCGAGATCTCCAAGCAGCTTCAGGCCGGATATGCTCTTCCCGTGGAGACGGATCCGCACAAGCGAGTCCGGTCGATTCTCACGCAAAGGGCACATACGTGGACGCACTGCGAA >UAMH11254_JN121816_Tsr1 CTGAGTCGGTGGGAGACATCCGAGGACCGCCCACACGAACCTGAAGATTGGCGTCGACTGCTTCAAATTGCTGATTATAAGGGCTCCAAAAACAAGGCTATCAGAGAAGCACTGGTTGGAGGTGTCGACCCTGGAAACCGTGTCGACGTTCACCTTCGGGCAGTACCAGCATCCCTTCGCAATCGGCCACAGCCAGTGTCCCTTTTCTCCCTCCTCCGCCATGAGCACAAACAGACAGTTGTCAACATAAGCATGTACCTCCACTCTGACGTCGAGGCACCCCTGAAGTCTAAGGAAGAGCTTCTCATCCAATGCGGACCACGCCGTCTGGTCGTGAACCCTATCTTTTCCGCCGGAGGCGTGACTCCAAACAACGTCCACAAATTCGACCGCTTCCTCCACCCCGGCCGGAGTGCCATCGCATCCTGGATCGGGCCTATGACCTGGGGTTCAGTGCCTGCCCTCGTCTTCAAAAACAAGCAAGTCCAAGACCCCGAAGTGATGGACTCAGCCGACGAAAACTCCGAGAACAAACCGACCATCGACCAACTGCAGCTGATCGGAACCGGAACCGTCGTCGCGCCTGACCAGTCTCGAGTCGTCGCCAAGCGAGCTATC |
IMAGES: